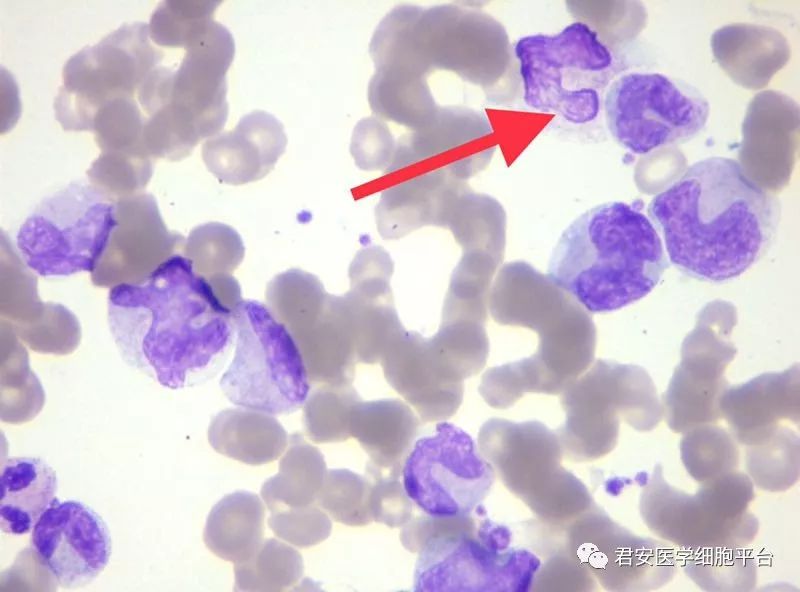
不同寻常的大细胞性贫血探因之路

巨幼细胞性贫血
282x280 - 9KB - JPEG

儿科学 第四节 营养性巨幼药细胞性贫血
288x288 - 18KB - JPEG

吃什么补血效果最好?科学正确补血方式介绍
443x282 - 413KB - PNG

食疗补血 女人身体最需要补这物--三九养生堂专
400x294 - 33KB - JPEG

营养性巨幼细胞性贫血(副本).ppt
1134x757 - 168KB - PNG

巨幼红细胞性贫血
300x240 - 11KB - JPEG

不同寻常的大细胞性贫血探因之路_诊断
800x526 - 33KB - JPEG
不同寻常的大细胞性贫血探因之路
800x592 - 46KB - JPEG

不同寻常的大细胞性贫血探因之路
800x592 - 29KB - JPEG

不同寻常的大细胞性贫血探因之路
800x592 - 47KB - JPEG

【女性贫血缺什么营养素】【图】女性贫血缺什
401x401 - 36KB - JPEG

不同寻常的大细胞性贫血探因之路
800x578 - 48KB - JPEG

临床执业医师
342x228 - 21KB - JPEG

巨幼细胞性贫血,巨幼细胞性贫血如何治疗,巨幼
300x220 - 13KB - JPEG

(图)巨幼细胞性贫血
1024x768 - 150KB - JPEG
简介:营养性巨幼红细胞性贫血又名营养性大细胞性贫血,镜下显示大细胞,正色素。多见于婴幼儿、尤其是2岁以内。什
正确答案:C 解析:1 .珠蛋白生成障碍性贫血属于小细胞性贫血 。2 .巨幼细胞性贫血属于大细胞性贫血 。3 .急性失血属于正细胞性贫血 。
根据红细胞的平均体积(MCV)及红细胞的平均血红蛋白浓度(MCHC)将贫血分为三类: (一) 大细胞性贫血 MCV>100fl,红细胞直径>10um。此类贫血大多为正常色素型。属于此类贫血的主要有叶酸或维生素B12缺乏引起的巨幼细胞贫血、溶血性贫血网织红细胞大量增多时、MDS的贫血、肝病及甲状腺功能减退的贫血等,原因各不相同。
主要是根据红细胞的平均体积(MCV)及红细胞的平均血红蛋白浓度(MCHC)将贫血分为三类:(一) 大细胞性贫血 MCV>100fl,红细胞直径>10um。此类贫血大多为正常色素型。属于此类贫血的主要有叶酸或维生素B12缺乏引起的巨幼细胞贫血、溶血性贫血网织红细胞大量增多时、肝病及甲状腺功能减退的贫血。(二) 正常细胞性贫血 MCV=80~100fl。此类贫血大多数为正常色素型,少数可有低色素型。属于此类贫血的主要为再生障碍性贫血、溶血性贫血及急性失血性贫血、脾功能亢进及慢性肾功能衰竭引起的贫血(三) 小细胞低色素性贫血 MCV<80fl、MCHC<32%。属于此类贫血的有缺铁性贫血、珠蛋白生成障碍性贫血(地中海贫血)、铁粒幼细胞贫血及某些慢性病贫血。
叶酸及维生素B12等)或者骨髓疾病等影响了造血。2.红细胞破坏过多:由于过度的红细胞被破坏,体内的代偿能力不足以弥补和维持红细胞生成与破坏之间的平衡。3.
大细胞性贫血是检验主管技师考试的内容,医学教育网搜集整理相关内容供大家参考。 (1)RDW正常:红细胞主峰右移,分布在75~130fl,波峰在100fl处
大细胞性贫血的定义是红细胞的平均体积大于100fl,红细胞直径大于10um。此类贫血大多为正常色素型。属于此类贫血的主要有叶酸或维生素B12缺乏引起的巨幼细胞贫血、溶
[摘要]目的:探讨大细胞性贫血(macrocytosis,MCV≥100 fl,男性成人Hb 125 g/L,女性成人Hb 105 g/L)的病因及形态学观察分析。方法:利用SYS-1800I血常规分析仪对2007年1月~
营养性巨幼红细胞性贫血(Nutritional Megaloblastic Anemia)又名营养性大细胞性贫血,多见于婴幼儿、尤其是2岁以内,我国华北、东北、西北 幼儿疾病精选 大细胞性贫血 首页